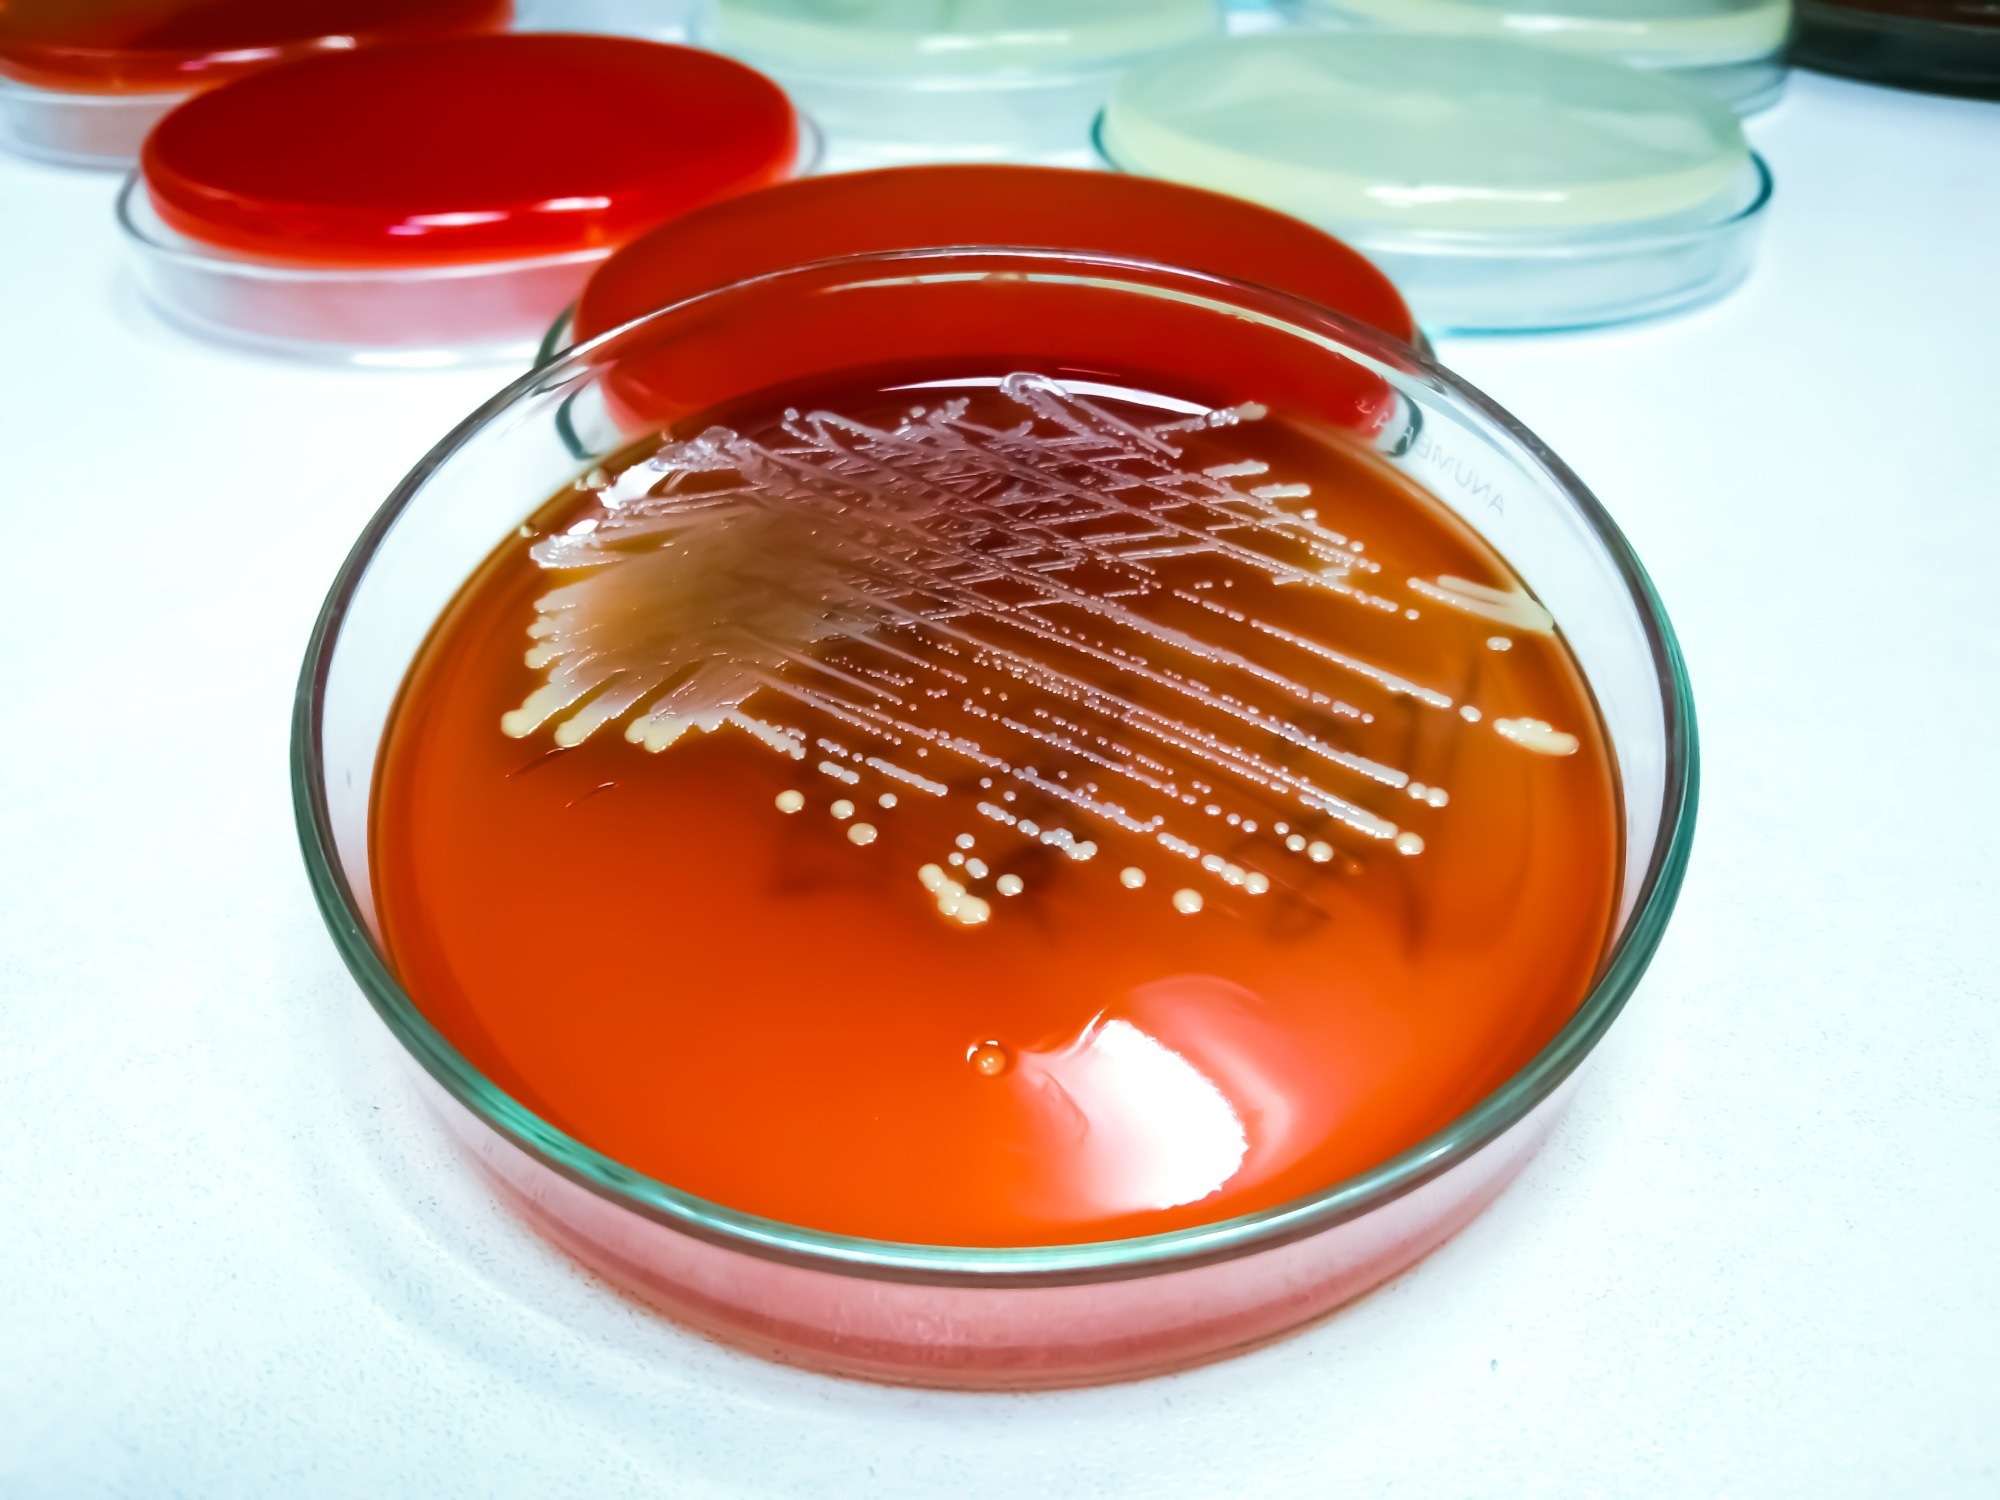
Staphylococcus aureus: Gram-positive, to Gram-variable, nonmotile, Coccus, beta hemolysis, saprotrophic bacterium.

A new study highlights the potential of light-activated curcumin to decrease resistance diversity in antibiotic-resistant Staphylococcus aureus, reinforcing photodynamic inactivation as a promising adjuvant therapy against bacterial infections.
Study: Photodynamic inactivation and its effects on the heterogeneity of bacterial resistance. Image Credit: Arif biswas/Shutterstock.com
Study: Photodynamic inactivation and its effects on the heterogeneity of bacterial resistance. Image Credit: Arif biswas/Shutterstock.com
A new light-based treatment could play a key role in combating antibiotic resistance. In a recent study published in Scientific Reports, researchers from Brazil and the United States explored photodynamic inactivation (PDI).
This technique uses light and photosensitizers to weaken resistant bacteria as a potential solution. They found that PDI significantly reduced the resistance diversity of Staphylococcus aureus, making antibiotics more effective.
Antibiotic-resistant bacteria
Antibiotic resistance is a growing global crisis, threatening the effectiveness of treatments for bacterial infections. Since the discovery of penicillin, antibiotics have saved millions of lives, but widespread misuse has also led to resistant bacterial strains.
Staphylococcus aureus, a common cause of infections especially, has developed resistance to multiple drugs, complicating treatment efforts and increasing the incidence of nosocomial infections.
Traditional approaches to combat antibiotic-resistant bacteria rely on stronger or combined antibiotics, yet resistance continues to evolve.
Bacteria can adapt rapidly through genetic mutations and gene transfer, making them resilient to treatment. Additionally, the presence of heterogeneous bacterial subpopulations further complicates therapy, as some cells survive and become more resistant while others die.
In the quest to find alternative strategies to enhance antibiotic efficacy, a promising approach involving photodynamic inactivation (PDI), which uses light-activated molecules to generate reactive oxygen species and damage bacterial cells, is being explored.
However, little is known about how PDI affects the heterogeneity of resistant bacterial populations.
About the study
In the present study, the researchers investigated the effects of PDI on antibiotic-resistant Staphylococcus aureus strains. They selected bacterial populations resistant to amoxicillin, gentamicin, and erythromycin.
Curcumin, a naturally derived photosensitizer, was used at a concentration of 10 µM, and they applied five PDI cycles using 450 nm light at an energy density of 10 Joules per cm².
To assess PDI’s impact, the minimum inhibitory concentration (MIC) of antibiotics was measured before and after light treatment. The MIC tests determine the lowest antibiotic concentration needed to inhibit bacterial growth, and changes in MIC values provided insights into PDI’s effect on bacterial resistance.
The study also analyzed bacterial population heterogeneity by modeling mortality curves using logistic functions. The researchers tracked how different subpopulations responded to light treatment by examining the width of survival curves.
A narrower distribution after PDI would indicate a more uniform response to antibiotics, suggesting reduced diversity in antibiotic resistance.
To maintain bacterial viability between PDI cycles, cultures were incubated for six-hour intervals before re-exposure. The methodology ensured that resistant bacteria were consistently exposed to controlled oxidative stress, allowing researchers to observe long-term effects.
The researchers also included controls such as untreated bacteria, bacteria exposed to curcumin without light, and bacteria exposed to light without curcumin.
Major findings
The study found that PDI significantly increased bacterial susceptibility to antibiotics. After five treatment cycles, the MIC values for amoxicillin, erythromycin, and gentamicin decreased, indicating that bacteria required lower antibiotic doses for inhibition.
Furthermore, PDI-treated bacterial populations exhibited a more homogeneous response to antibiotics, with reduced resistance diversity.
A key finding was the narrowing of survival curve widths. In untreated populations, the MIC values varied widely, reflecting a heterogeneous response among resistant subpopulations. Post-PDI, this variability decreased, suggesting that bacterial populations became more uniform and easier to target with antibiotics.
For methicillin-resistant Staphylococcus aureus (MRSA), which is the major cause of nosocomial infections, the distribution width reduced by 76.52%, while antibiotic-induced resistant strains showed reductions exceeding 90%.
The most significant improvement was seen in gentamicin-resistant strains, where the heterogeneity decreased by 99.84%.
Furthermore, mathematical modeling confirmed that PDI altered the bacterial survival dynamics without eliminating the resistant strains. Instead, it weakened subpopulations, making them more vulnerable to antibiotics. This finding supported the idea that PDI does not act as a standalone treatment but as an adjuvant therapy that enhances antibiotic effectiveness.
However, the findings indicated some limitations as well. While PDI successfully reduced resistance heterogeneity, its effectiveness varied by antibiotic type and bacterial strain.
Some strains remained more resilient than others, suggesting that further optimization of PDI protocols may be necessary before widespread applications of the technology can occur. Additionally, real-world applications will require clinical validation to assess safety and feasibility.
Conclusions
Overall, the study suggested that PDI was a promising tool in the fight against antibiotic-resistant bacteria. By reducing bacterial heterogeneity and enhancing antibiotic susceptibility, PDI offers a potential strategy to improve treatment outcomes.
The findings also indicated that future research should focus on optimizing PDI protocols and integrating them into clinical settings. If proven effective in human applications, this approach could revolutionize infection management and slow the spread of resistant bacterial strains.